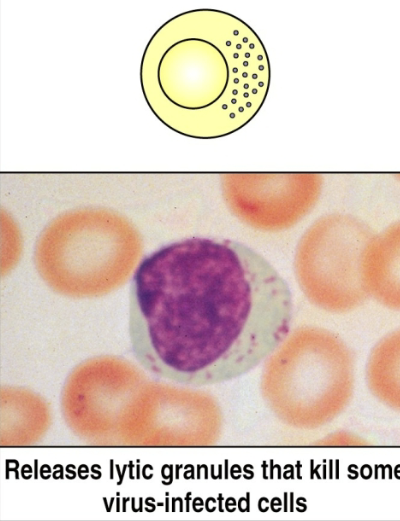

1/67
Looks like no tags are added yet.
Name | Mastery | Learn | Test | Matching | Spaced |
|---|
No study sessions yet.
hematopoiesis
blood cell production
hematopoietic stem cells (HSC)
multipotent, give rise to all blood cells. when they differentiate, they form 2 lineages: myeloid progenitor cells (MPCs) & lymphoid progenitor cells (LPCs)

myeloid progenitor cells (MPCs)
differentiate into RBCs, platelets, neutrophils, monocytes, eosinophils, basophils, mast cells, and certain dendritic cells
lymphoid progenitor cells (LPCs)
differentiate into T & B lymphocytes and specific dendritic cells
hematopoietic homeostatic mechanism
to keep a steady state level, the number of cells that arise from division & differentiation are equal to the number of cells removed by cell death
what regulates the steady state of hematopoiesis?
levels & types of cytokines produced by bone marrow stromal cell
cytokines produced by activated cells (macrophages, T cells)
regulation of receptor expression by stem & progenitor cells
controlled cell death (apoptosis). many WBCs are produced per day, neutrophils survive a few days & are removed by apoptosis
there is no steady state level because during infection…
white blood cells increase. the immune system cannot sustain such a massive increase in cell number for extended periods of time, so unwanted (excess) activated lymphocytes are removed by apoptosis after infection
types of lymphocytes
B cells, natural killer cells (NK), T cells (helper & cytotoxic)

natural killer (NK) cells
lymphocytes that can kill host cells (e.g. virus-infected cells) without making their own antigen-specific receptor (do not require Ab or TCR). innate immunity only
CD markers/antigens
“cluster of differentiation”. specific types of molecules found on the surface of cells that help differentiate one cell type from another
CD4
adhesion molecule that binds to class II MHC molecules; signal transduction. usually on T helper cells
CD8
adhesion molecule that binds to class I MHC; signal transduction. usually on T helper & T cytotoxic cells
monocytes differentiating into macrophages
2-12% of WBCs. increase in size 5 to 10 fold. increased phagocytic ability. high level of hydrolytic enzymes. secretes variety of soluble factors

macrophages
are professional antigen presenting cells. can be tissue-specific, so they can have different functions depending on where they are in the body
microglia
in the brain. neural circuit development (synaptic pruning). type of macrophage
alveolar macrophage
in the lungs. removes pollutants & microbes, clears surfactants
kupffer cell
in the liver. scavenge red blood cells, clear particles
resident kidney macrophage
in the kidney. regulate inflammatory responses to antigen filtered from the blood
langerhans cell
in the skin. skin immunity & tolerance. type of dendritic cell.
red pulp macrophage
in the spleen. scavenge red blood cells, recycle iron
peritoneal cavity macrophage
in peritoneal cavity. maintain IgA production by B-1 B cells
lamina propria macrophage
in the intestines. gut immunity & tolerance
intestinal muscularis macrophage
in the intestines. regulate peristalsis
bone marrow macrophage
in the bone marrow. maintain niche for blood cell development, clear neutrophils
subcapsular sinus macrophage
in lymph nodes. trap antigen particles
cardiac macrophage
in the heart. clear dying heart cells
activated macrophages
digest exogenous antigen. use oxygen-dependent killing by reactive oxygen intermediates (ROI). perform oxygen-independent killing via various hydrolytic enzymes. have antimicrobial & cytotoxic peptides called defensins. secrete tumor necrosis factor-alpha (TNF-alpha). express high levels of MHC II & peptide complex + MHC II (antigen presentation).

respiratory burst
process by which reactive oxygen intermediates (ROI) are produced. membrane bound oxidase catalyzes reduction of oxygen to superoxide anion. superoxide anion also generates other powerful oxidizing agents (hydroxyl ion, bleach, H2O2, etc)

phagocytosis
cell eating. macrophages have receptors for antibody (Fc receptor) & complement (CR1). antigen coated with antibody binds to macrophages, which then gets eaten

opsonization
process by which particulate antigens are rendered susceptible to phagocytosis

opsonin
molecule (antibody or complement component (C3b) that binds to an antigen and macrophage, enhancing phagocytosis
neutrophils (PMN)
granulocytic cell. 50-70% of circulating leukocytes. increased during infection. first to arrive at site of inflammation. kill microorganisms. makes hypochlorous acid (bleach) like other oxidizing agents.

eosinophils
granulocytic cell. 1-3% of leukocytes. phagocytic cells. bilobed nuclei. defense against parasitic organisms

mast cells & basophils
play a crucial role in inflammatory & immediate allergic responses. release potent inflammatory mediators (histamine, proteases, chemotaxic factors, cytokines, metabolites of arachidonic acid) that act on vasculature, smooth muscle, connective tissues, mucous glands, inflammatory cells.

basophils
least numerous of the leukocytes; > 1% are present in circulating blood
mast cells
leave the bone marrow undifferentiated, enter tissues & then become these cells. found in mucosal epithelium, skin, & various organs
dendritic cells
antigen-presenting cells (APC) & are classified according to their location. capture antigen in tissues and then go to lymphoid organs to present the antigen to T lymphocytes. more potent APCs than macrophages or B cells.

interstitial dendritic cells
in connective tissue of most organs
interdigitating dendritic cells
in lymphoid tissues
circulating dendritic cells
in bloodstream
follicular dendritic cells
in lymph nodes
types of dendritic cells
MHC I, MHC II, B7 (CD80 & CD86), CD40
primary lymphoid organs
sites of lymphocyte maturation: thymus, bone marrow

thymus
size peaks at puberty & decreases as people age. arranged into an outer, more cellular cortex, and an inner, less cellular medulla. immature lymphoid cells enter cortex where they proliferate, mature & pass on into medulla. from medulla, mature T cells enter the circulation

T cell receptor rearrangement
the elimination of T cells that cannot recognize antigen-MHC complex & that recognize self antigens
lack of thymus results in…
loss of T-lymphocyte development (digeorge’s syndrome: congenital birth defect in humans, nude mice). loss of antibody formation that requires helper T cells, cell-mediated immune responses. increase in infections.
bone marrow
B cell development occurs during embryonic development in the liver and is maintained later in here. in humans, B cell development is complete & B cells are functionally mature when they exist here.

lymphatic system
pathogens from site of infection reach lymph nodes via lymphatics. native lymphocytes arrive at lymph nodes in arterial blood. lymphocytes & lymph return to the blood via the lymphatics. venous blood returns to the heart. figured out we have one of these in the brain in 2015.

lymphatic system pathway to lymph
blood from smooth muscle goes through blood capillaries. oxygen in capillaries reaches lymphatic capillaries and move through lymph. deoxygenated blood from capillaries goes through venules

secondary lymphoid organs
site of lymphocyte activation: lymph nodes, mucosal associated lymphoid tissue (MALT), spleen
lymph node layers
cortex (outermost layer), paracortex (layer just beneath cortex), medulla (innermost layer)

lymph nodes
naive lymphocytes sample stromal cells in here. B & T cells are guided by different chemokine interactions to distinct microenviornments: B cells enter follicles, T cells enter paracortex. here, they will scan for antigens using their Ag receptors.

high endothelial venules (HEV)
from the blood, lymphocytes arrive at the lymph node through these (specialized endothelial cells). cells move into lymph node by extravasation process

fibroblastic reticular cell conduit system
network of collagen & extracellular matrix (ECM) fibers within lymph nodes & other secondary lymphoid organs. they are formed and maintained by fibroblastic reticular cells (FRCs)

cortex of lymph nodes
contains mostly B cells, follicular dendritic cells, & macrophages arranged in clusters called primary follicles. aka thymus independent area.
germinal center (GC)
inside lymph nodes. contains proliferating B cells & plasma cells interspersed with macrophages & dendritic cells.

spleen
filers blood & removes old/damaged RBCs, platelets, & WBCs. stores RBCs & releases them into circulation when needed. produces WBCs to fight infection: immune response against blood borne antigens. contains white pulp & red pulp

red pulp
contains macrophages & RBCs. site where old & defective RBCs are destroyed
white pulp
surrounds the splenic artery forming the periarteriolar lymphoid sheath (PALS) that is populated with many T cells, primary follicles, & marginal zone.
primary lymphoid follicles
attached to PALS. rich in B cells, some of which are within the germinal center
marginal zone
peripheral to PALS and contains macrophages & lymphocytes
process in the spleen
antigen & lymphocytes —> marginal zone —> dendritic cells process antigen —> activation of B cells & T helper cells occurs in PALS —> activated B cells w/ some T helper cells migrate to primary follicle, forming characteristic secondary follicle, which then forms germinal center

mucosal-associated lymphoid tissue (MALT)
organized lymphoid tissues in the mucous membranes lining the digestive, respiratory, & urogenital tract. ex: GALT (GI), BALT (bronchus), SALT (skin)

gut-associated lymphoid tissue (GALT)
specialized lymphoid tissues in the gastrointestinal tract, which are a crucial part of the body’s defense system against pathogens. they act as immune sentinels: constantly sampling the gut’s contents to initiate immune responses to harmful pathogens & maintain a state of tolerance towards harmless antigens

peyer’s patch
present in the submucosal layer of the digestive tract & has 30-40 lymphoid follicles. contains M cells
M cells
transport antigens from the cavity of digestive, respiratory, & urogenital areas to the organized lymphoid area (MALT, GALT, etc). capture the antigen & transport it to the lumen side

tonsils
organized into follicles surrounded by T cells in the mouth. present as lingual at the base of the tongue, palatine at the sides & back of the mouth, and nasopharyngeal (adenoids) in the roof of the nasopharynx
cutaneous/skin-associated lymphoid tissue (SALT)
langerhans cells trap antigens & migrates to the regional lymphnodes and present them to T cells, which are also present as intraepithelial lymphocytes.
